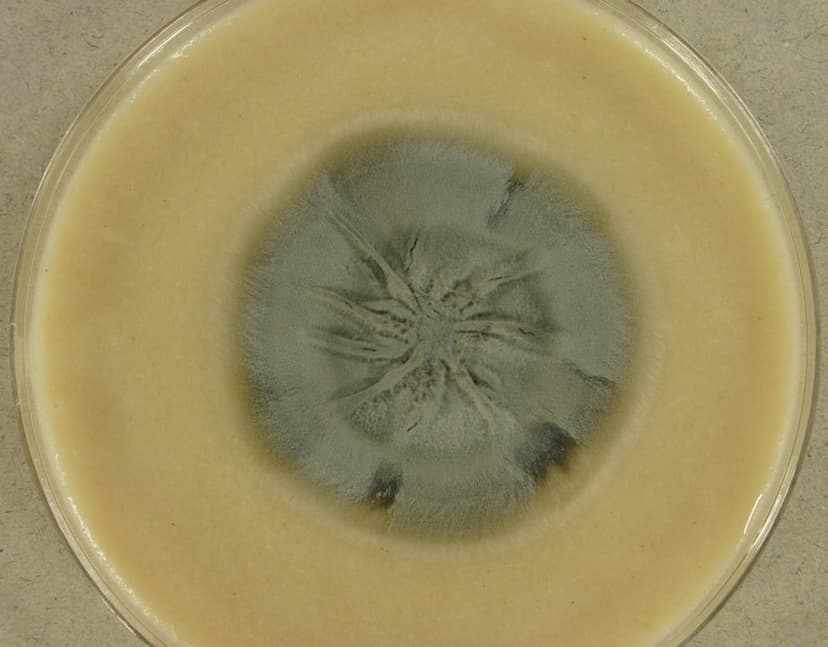
اوئیدیودندرون

اوئیدیودندرون
اوئیدیودندرون: کلنی آن دارای رشد متوسط و متمایل به قهوهای است. دارای کونیدیوفورهای با دیواره صاف یا خشن و بصورت منفرد یا گروهی هستند. کونیدیوفورها در راس خود با تقسیمات مکرر ایجاد شبکهای از میسلیومهای زایشی مینمایند. کونیدیوفورها قهوهای میباشند. میسلیومهای بارور ظریف و شفاف بوده و با ایجاد تیغههای میانی فراوان با فواصل کم بصورت آرتروکونیدیا دیده میشوند. آرتروکونیدیا تک سلولی بوده دارای سطحی صاف یا خشن میباشند و به اشکال کروی، نیمه کروی، تخم مرغی شکل و یا استوانه مانند هستند.